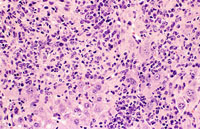
Myelodysplasia
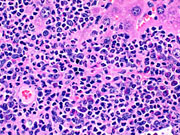
Myelodysplasia

The Digitized Atlas of Mouse Liver Lesions

Much of the work carried out by DTT is in support of the National Toxicology Program (NTP), an interagency partnership of the Food and Drug Administration, National Institute for Occupational Safety and Health, and NIEHS.
Visit the NTP WebsiteA spectrum of lesions affecting the liver and other tissues has been observed in Tg.AC mice treated with rotenone. The lesions appear to represent a morphological and biological continuum with varying features of hematopoietic, inflammatory, and neoplastic processes. The cellular infiltrates consist of a mixture of immature and mature myeloid cells and mononuclear cells including plasma cells, often with a striking eosinophil component. The granulocytic infiltrates are often immature and megakarocytes as well as erythropoietic foci may be present. Hyaline degeneration and proliferation of bile ducts has been noted in some cases.
Myelodysplasia with primarily periportal myeloproliferation. Higher magnification shows bridging of cellular infiltrates between portal areas and hyaline degenerative changes in hepatocytes.
Low magnification of severe myeloproliferative infiltration of the liver. Higher magnification shows dense cellular infiltrates and destruction of hepatocytes. A large number of mature eosinophils are evident.
Another case of myelodysplasia. Numerous granulocytes with eosinophilic granular cytoplasm and a smaller number of mononuclear cells are visible in the high magnification view.
Another example of myelodysplasia from a Tg.AC mouse on a FVB background, treated with rotenone.